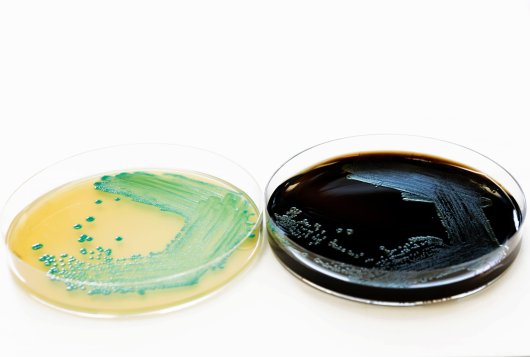
Listeria monocytogenes Growth Relevant to Minimally Processed Vegetables

RESEARCH RESULTS
Listeria monocytogenes Growth Relevant to Minimally Processed Vegetables
For minimally processed vegetables, manufacturers should demonstrate that Listeria monocytogenes (Lm) levels will not exceed 100 cfu/g during shelf life. Challenge tests provide information on the growth behavior of Lm on a product. Technical guidance at EU level describes the use of Lm reference strain(s) from a characterized strain set. This strain set does not include isolates from vegetable products. Information on maximum growth rates of Lm strains isolated from vegetable products can be used for selection of relevant strains in challenge test and allows for more accurate prediction of expected cell numbers in growth models.
About the research
A set of 37 Lm strains previously isolated from vegetable products or its process environment were characterized for maximum growth rate at 8°C in a culture broth and for a selection of strains on iceberg lettuce. Experimentally determined growth rates were compared to data from literature and are in line with those reported for leafy greens.
Relevance for the sector
Growth rates of Listeria monocytogenes isolates from vegetables have been determined in broth and on iceberg lettuce and can be used for more accurate prediction of growth on minimally processed vegetables.
More information?
How to maintain high product quality of fruit and vegetables while reducing the use of chemical pesticides and environmentally harmful packaging? How do cooperating parties in the chain ensure they can continue supplying fresh, high-quality products? And to what extent van this increase consumption of fruit and vegetables? These and other research questions were examined in the Fresh on Demand project.
Fresh on Demand is co-financed by the Ministry of Agriculture, Nature and Food Quality (TKI, Top Consortia for Knowledge and Innovation), Fresh Produce Center and an extensive group of private companies from growers to suppliers of sensors and technologies.
Curious to learn more about the results of the project or what experts of Wageningen University & Research can do for your company? Please contact our experts.

FreshKnowledge Team